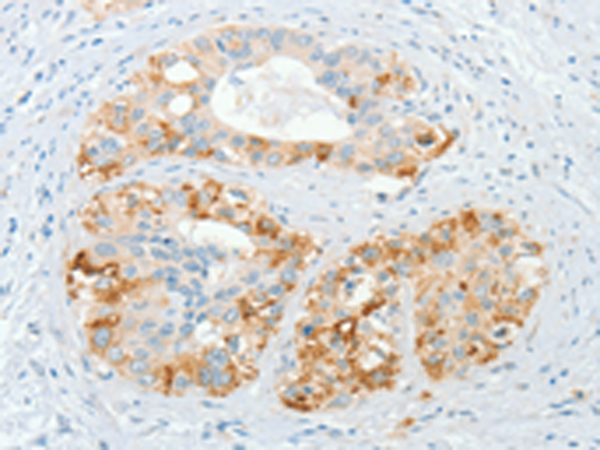

别名:BNF1; CHL2; FKSG37应用:IHC
反应种属:Human
规格:50μl/100μl
| Description |
|---|
| CHRDL2 (chordin-related protein 2), also known as BNF1 (breast tumor novel factor 1) or CHL2 (chordin-like 2), is a 429 amino acid protein that belongs to the chordin family of proteins. CHRDL2 contains three VWFC (von Willebrand Factor type C) domains and is predominantly expressed in uterus and moderately expressed in prostate, liver, ovary, heart and testis. Due to alternative splicing events, CHRDL2 exists as five isoforms, namely isoform I, isoform II, isoform VII, isoform VIII and isoform IX. Two of these isoforms are secreted, while the other three localize to the cytoplasm. Functioning as a BMP-binding inhibitor, CHRDL2 directly interacts with BMPs and blocks their binding to BMP receptors, thereby inhibiting BMP activity. In breast, lung and colon tumors, CHRDL2 expression is upregulated, suggesting a possible role in tumorigenesis. |
| Specification | |
|---|---|
| Aliases | BNF1; CHL2; FKSG37 |
| Swissprot | Q6WN34 |
| Host/Isotype | Rabbit IgG |
| Storage | Store at 4°C short term. Aliquot and store at -20°C long term. Avoid freeze/thaw cycles. |
| Species Reactivity | Human |
| Immunogen | Synthetic peptide of human CHRDL2 |
| Formulation | pH7.4 PBS, 0.05% NaN3, 40% Glycerol |
| Application | |
|---|---|
| IHC | 1/25-1/100 |
| ELISA | 1/2000-1/5000 |
![]() |
The image is immunohistochemistry of paraffin-embedded Human liver cancer tissue using P11662(CHRDL2 Antibody) at dilution 1/20. (Original magnification: ×200) |
![]() |
The image is immunohistochemistry of paraffin-embedded Human cervical cancer tissue using P11662(CHRDL2 Antibody) at dilution 1/20. (Original magnification: ×200) |
本公司的所有产品仅用于科学研究或者工业应用等非医疗目的,不可用于人类或动物的临床诊断或治疗,非药用,非食用。
暂无评论
本公司的所有产品仅用于科学研究或者工业应用等非医疗目的,不可用于人类或动物的临床诊断或治疗,非药用,非食用。
中文

发表回复